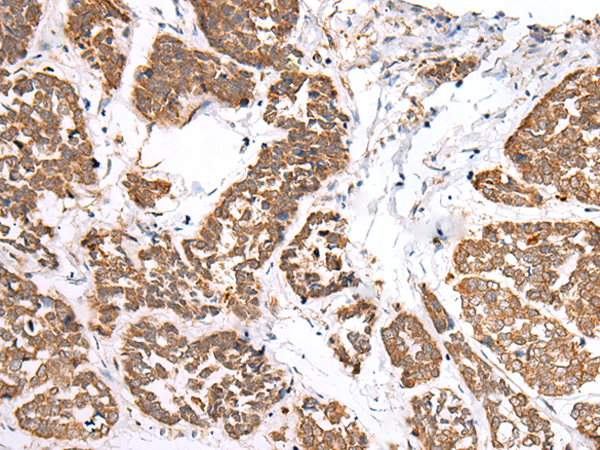

|
Background: |
This gene encodes a G protein-coupled receptor of mammalian phagocytic cells that is a member of the G-protein coupled receptor 1 family. The protein mediates the response of phagocytic cells to invasion of the host by microorganisms and is important in host defense and inflammation. |
|
Applications: |
ELISA, IHC |
|
Name of antibody: |
FPR1 |
|
Immunogen: |
Synthetic peptide of human FPR1 |
|
Full name: |
formyl peptide receptor 1 |
|
Synonyms: |
FPR; FMLP |
|
SwissProt: |
P21462 |
|
ELISA Recommended dilution: |
2000-5000 |
|
IHC positive control: |
Human esophagus cancer |
|
IHC Recommend dilution: |
25-100 |
購(gòu)物車
幫助
021-54845833/15800441009
